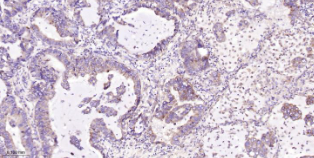

Human EIF2S1 Ready-To-Use IHC Kit
Human EIF2S1 Ready-To-Use IHC Kit
Cat. No.: IHC0645HSample Type: FFPE tissue
Size: 50T (including a control slide)
Storage and Stability: Please store components at the temperatures indicated on the individual tube labels. The kit is stable for 6 months from the date of receipt.
Background
EIF2a (Eukaryotic translation initiation factor 2A) is a heterotrimer composed of three subunits (alpha, beta, and gamma). This translation initiation factor drives binding of initiator methionyl-tRNA to the 40S ribosome in an AUG-dependent manner to form the 43S pre-initiation complex. The polypeptide can be phosphorylated by related protein kinases activated in response to stress. Phosphorylated EIF2A inhibits EIF2B activity and prevents guanine nucleotide exchange.
Synonyms
0910001O23Rik; 2410026C18Rik; 35kDa; EIF-2; EIF-2A; EIF-2alpha; EIF2; EIF2A; eIF2alpha; EIF2S1; eukaryotic translation initiation factor 2 subunit 1.Validation Data
Materials Supplied
| Number | Component | 50T | Concentration | Storage |
|---|---|---|---|---|
| 1 | PBS Buffer (powder) | 2L x 2 | 20x | RT |
| 2 | Antigen Retrieval Buffer | 20ml | 100x | 2-8°C |
| 3 | Endogenous Peroxidase Blocking Buffer | 3ml | RTU | 2-8°C |
| 4 | Blocking Buffer | 3ml | RTU | 2-8°C |
| 5 | Primary Antibody (Human EIF2S1 Recombinant Rabbit mAb) | 6ml | RTU | 2-8°C |
| 6 | Secondary Antibody (Goat Anti-Rabbit IgG H&L, HRP conjugated) | 6ml | RTU | 2-8°C |
| 7 | Chromogen Component A | 0.3ml | RTU | -20°C |
| 8 | Chromogen Component B | 0.3ml | RTU | -20°C |
| 9 | Counter Staining Reagent | 5ml | RTU | RT |
| 10 | Differentiation Reagent | 6ml | RTU | RT |
| 11 | Mounting Media | 5ml | RTU | RT |
| 12 | Control slide (Human breast cancer) | 1 slide | RTU | RT |
| 13 | Datasheet | 1 copy |
Notes
- The positive control slide provided in the kit allows you to be sure that the experimental set-up is working properly.
- Do not allow slides to dry at any time during this procedure.
- Please don't replace the matching reagents in this product with other manufacturers' products.
- As DAB is a carcinogen, please take necessary precautions.
- PBS (reagent 1) can be stored for one week at 4℃ after preparation; The antigen retrieval buffer (1×reagent 2) and the chromogenic agent (the mixture of reagents 7 and 8) should be prepared right before each assay.
As DAB is a carcinogen, please take necessary precautions.
Important Note: This product as supplied is intended for research use only, not for use in human, therapeutic or diagnostic applications.